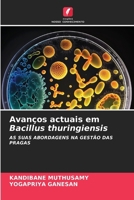
Avanços actuais em Bacillus thuringiensis 6202193689 Book Cover

- Außerblütige Nektarien auf biologischen Bekämpfungsmitteln (German Edition)
- Nettari extrafloreali su agenti di controllo biologico (Italian Edition)
- Nectaires extrafloraux sur les agents de lutte biologique (French Edition)
- Nectários extraflorais em agentes de controlo biológico (Portuguese Edition)
- INSECTES INDUCTEURS DE GALLE : DE L'ANATOMIE À LA BIODIVERSITÉ ET À LA GESTION (French Edition)